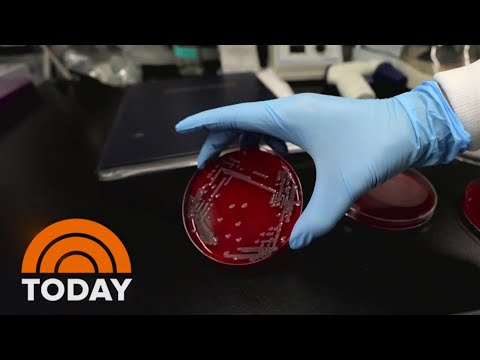
Biotechnology Innovations in Cosmetology | Cosmetologist.org

Contents
- 📖 Introduction to Biotechnology Innovations
- 🧬 Understanding Biotechnology in Cosmetology
- 💡 Biotechnology Applications in Cosmetology
- 🌿 Plant-Based Biotechnology in Cosmetology
- 🧴 Microbiome-Focused Biotechnology in Cosmetology
- 💻 Digital Biotechnology in Cosmetology
- 🎯 Implementing Biotechnology Innovations in Your Practice
- 📈 Measuring the Success of Biotechnology Innovations
- 🤝 Collaboration and Education in Biotechnology Innovations
- 📊 Future Directions in Biotechnology Innovations
- 📚 Conclusion and Next Steps
- Frequently Asked Questions
- Related Topics
Overview
Biotechnology innovations are revolutionizing the cosmetology industry, offering new and exciting ways to enhance beauty and skincare. From gene editing to stem cell therapy, these advancements are changing the way we approach beauty treatments. For instance, biotech-based skincare products are now being formulated with microorganisms that can help balance the skin's microbiome, leading to healthier and more radiant skin. Try this: research the latest biotech-based skincare products and explore how they can be incorporated into your practice. As a cosmetologist, it's essential to stay up-to-date on these innovations to provide the best possible services to your clients. With the rise of biotechnology in cosmetology, the future of beauty is looking brighter than ever, with potential applications in hair growth, nail care, and makeup artistry, and a growing number of cosmetology schools and programs now offering courses in biotechnology and its applications in the beauty industry.
📖 Introduction to Biotechnology Innovations
The field of cosmetology is constantly evolving, with new technologies and innovations emerging every year. One of the most exciting areas of development is biotechnology, which is being used to create new and improved products and treatments. In this lesson, we will explore the world of biotechnology innovations in cosmetology, including the latest applications, benefits, and best practices. To get started, let's define what biotechnology is and how it is being used in the beauty industry. Check out our article on cosmetology license requirements to learn more about the basics of the field. We will also discuss the importance of salon management in implementing new technologies. Try this: research different types of biotechnology and how they are being used in various industries, including hair styling and makeup artistry.
🧬 Understanding Biotechnology in Cosmetology
Biotechnology is the use of biological systems, living organisms, or derivatives thereof, to develop new products and technologies. In cosmetology, biotechnology is being used to create new and improved products, such as skincare creams and serums, hair care products, and color cosmetics. For example, biotechnology is being used to develop new ingredients, such as peptides and stem cells, that can help to improve the appearance and health of the skin and hair. Check out our article on skincare routines to learn more about how biotechnology is being used in this area. We will also discuss the role of nail care in overall beauty and wellness. Try this: think about how biotechnology could be used to solve common problems in the beauty industry, such as cosmetology schools and training programs.
💡 Biotechnology Applications in Cosmetology
One of the most exciting areas of biotechnology innovation in cosmetology is the development of new ingredients and products. For example, biotechnology is being used to develop new types of skincare products that contain ingredients such as peptides, stem cells, and growth factors. These ingredients can help to improve the appearance and health of the skin, reducing the signs of aging and improving skin texture and tone. Check out our article on career paths for cosmetologists to learn more about the different areas of the industry where biotechnology is being used. We will also discuss the importance of salon management in implementing new technologies and products. Try this: research different types of biotechnology-based products and how they are being used in the beauty industry, including hair styling and makeup artistry.
🌿 Plant-Based Biotechnology in Cosmetology
Plant-based biotechnology is another area of innovation in cosmetology. This involves the use of plants and plant-derived ingredients to develop new products and treatments. For example, plant-based biotechnology is being used to develop new types of skincare products that contain ingredients such as botanical extracts and plant stem cells. Check out our article on skincare routines to learn more about how plant-based biotechnology is being used in this area. We will also discuss the role of nail care in overall beauty and wellness. Try this: think about how plant-based biotechnology could be used to solve common problems in the beauty industry, such as sustainability and environmental impact. Check out our article on cosmetology schools to learn more about training programs in this area.
🧴 Microbiome-Focused Biotechnology in Cosmetology
Microbiome-focused biotechnology is another area of innovation in cosmetology. This involves the study of the microbiome, or the community of microorganisms that live on and inside the human body. Biotechnology is being used to develop new products and treatments that take into account the microbiome and its role in human health and beauty. Check out our article on career paths for cosmetologists to learn more about the different areas of the industry where microbiome-focused biotechnology is being used. We will also discuss the importance of salon management in implementing new technologies and products. Try this: research different types of microbiome-focused biotechnology products and how they are being used in the beauty industry, including hair styling and makeup artistry.
💻 Digital Biotechnology in Cosmetology
Digital biotechnology is also being used in cosmetology, particularly in the area of personalized beauty and skincare. This involves the use of digital technologies, such as artificial intelligence and machine learning, to develop personalized skincare routines and product recommendations. Check out our article on skincare routines to learn more about how digital biotechnology is being used in this area. We will also discuss the role of nail care in overall beauty and wellness. Try this: think about how digital biotechnology could be used to solve common problems in the beauty industry, such as product matching and customer engagement. Check out our article on cosmetology schools to learn more about training programs in this area.
🎯 Implementing Biotechnology Innovations in Your Practice
Implementing biotechnology innovations in your practice can seem daunting, but there are many resources available to help. Check out our article on salon management to learn more about how to implement new technologies and products in your salon. We will also discuss the importance of career paths for cosmetologists in the beauty industry. Try this: research different types of biotechnology-based products and how they are being used in the beauty industry, including hair styling and makeup artistry. Check out our article on cosmetology schools to learn more about training programs in this area.
📈 Measuring the Success of Biotechnology Innovations
Measuring the success of biotechnology innovations in cosmetology can be challenging, but there are many metrics that can be used. Check out our article on skincare routines to learn more about how to measure the effectiveness of biotechnology-based products. We will also discuss the role of nail care in overall beauty and wellness. Try this: think about how you can use data and metrics to measure the success of biotechnology innovations in your practice. Check out our article on cosmetology schools to learn more about training programs in this area.
🤝 Collaboration and Education in Biotechnology Innovations
Collaboration and education are key to the successful implementation of biotechnology innovations in cosmetology. Check out our article on career paths for cosmetologists to learn more about the different areas of the industry where biotechnology is being used. We will also discuss the importance of salon management in implementing new technologies and products. Try this: research different types of biotechnology-based products and how they are being used in the beauty industry, including hair styling and makeup artistry. Check out our article on cosmetology schools to learn more about training programs in this area.
📊 Future Directions in Biotechnology Innovations
The future of biotechnology innovations in cosmetology is exciting and rapidly evolving. Check out our article on skincare routines to learn more about the latest trends and developments in the field. We will also discuss the role of nail care in overall beauty and wellness. Try this: think about how you can stay up-to-date with the latest developments in biotechnology innovations and how you can apply them in your practice. Check out our article on cosmetology schools to learn more about training programs in this area.
📚 Conclusion and Next Steps
In conclusion, biotechnology innovations are transforming the field of cosmetology, offering new and exciting opportunities for beauty professionals. By understanding the basics of biotechnology and its applications in cosmetology, you can stay ahead of the curve and provide your clients with the latest and most effective treatments and products. Check out our article on career paths for cosmetologists to learn more about the different areas of the industry where biotechnology is being used. We will also discuss the importance of salon management in implementing new technologies and products. Try this: think about how you can apply the concepts and techniques learned in this lesson to your own practice and how you can continue to learn and grow in the field of biotechnology innovations in cosmetology.
Key Facts
- Year
- 2022
- Origin
- Cosmetologist.org
- Category
- Best Practices
- Type
- Educational Resource
Frequently Asked Questions
What is biotechnology and how is it being used in cosmetology?
Biotechnology is the use of biological systems, living organisms, or derivatives thereof, to develop new products and technologies. In cosmetology, biotechnology is being used to create new and improved products, such as skincare creams and serums, hair care products, and color cosmetics. Check out our article on cosmetology license requirements to learn more about the basics of the field. We will also discuss the importance of salon management in implementing new technologies and products.
What are some examples of biotechnology-based products in cosmetology?
Some examples of biotechnology-based products in cosmetology include skincare products that contain ingredients such as peptides, stem cells, and growth factors. Check out our article on skincare routines to learn more about how biotechnology is being used in this area. We will also discuss the role of nail care in overall beauty and wellness.
How can I implement biotechnology innovations in my practice?
Implementing biotechnology innovations in your practice can seem daunting, but there are many resources available to help. Check out our article on salon management to learn more about how to implement new technologies and products in your salon. We will also discuss the importance of career paths for cosmetologists in the beauty industry.
What are some metrics that can be used to measure the success of biotechnology innovations in cosmetology?
Some metrics that can be used to measure the success of biotechnology innovations in cosmetology include customer satisfaction, product sales, and social media engagement. Check out our article on skincare routines to learn more about how to measure the effectiveness of biotechnology-based products.
How can I stay up-to-date with the latest developments in biotechnology innovations in cosmetology?
To stay up-to-date with the latest developments in biotechnology innovations in cosmetology, you can attend industry conferences, read industry publications, and follow industry leaders on social media. Check out our article on cosmetology schools to learn more about training programs in this area.